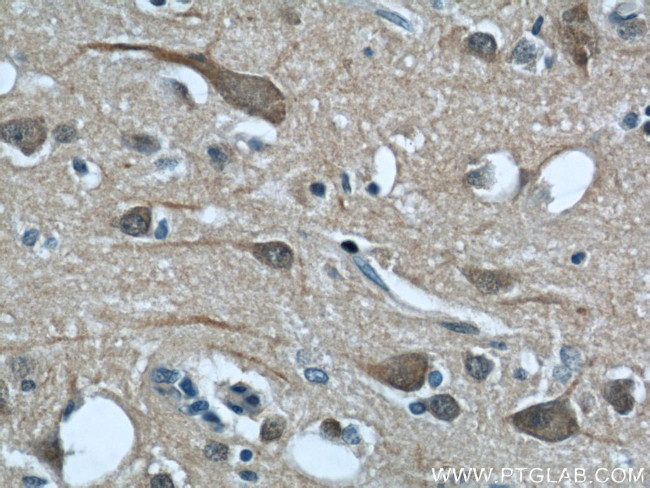
CALHM1 Antibody in Immunohistochemistry (Paraffin) (IHC (P))

Search
Proteintech
CALHM1 Polyclonal Antibody
{{$productOrderCtrl.translations['antibody.pdp.commerceCard.promotion.promotions']}}
{{$productOrderCtrl.translations['antibody.pdp.commerceCard.promotion.viewpromo']}}
{{$productOrderCtrl.translations['antibody.pdp.commerceCard.promotion.promocode']}}: {{promo.promoCode}} {{promo.promoTitle}} {{promo.promoDescription}}. {{$productOrderCtrl.translations['antibody.pdp.commerceCard.promotion.learnmore']}}
产品信息
22042-1-AP
种属反应
宿主/亚型
分类
类型
抗原
偶联物
形式
浓度
规格
纯化类型
保存液
内含物
保存条件
运输条件
产品详细信息
Immunogen sequence: CTEHAKAFA KVCIQQFFEA MNHDLELGHT NGTLATAPAS AAAPTTPDGA EEEREKLRGI TDQGTMNRLL TSWHKCKPPL RLGQEEPPLM GNGWAGGGPR PPRKEVATYF SKV (235-346 aa encoded by BC036193)
靶标信息
Alzheimers disease (AD) is a progressive neurodegenerative disorder characterized by a massive loss of neurons in several brain regions and by the presence of senile plaques comprised of aggregated amyloid-beta (Abeta) peptides produced by the endoproteolysis of the amyloid precursor protein (APP). The calcium homeostasis modulator 1 (CALHM1) is a recently identified multipass transmembrane glycoprotein that controls cytosolic Ca2+ concentration and Abeta levels. While some studies suggest CALHM1 is significantly associated with risk of AD, other reports suggest there is no link. CALHM1 has been suggested to modulate the Ca2+-dependent proteolytic process of APP through controlling the level of cytosolic Ca2+.
仅用于科研。不用于诊断过程。未经明确授权不得转售。
篇参考文献 (0)
生物信息学
蛋白别名: Calcium homeostasis modulator protein 1; family with sequence similarity 26, member C; Protein FAM26C
基因别名: CALHM1; EG546729; FAM26C; RGD1564891
UniProt ID: (Human) Q8IU99, (Mouse) D3Z291
Entrez Gene ID: (Human) 255022, (Rat) 499367, (Mouse) 546729